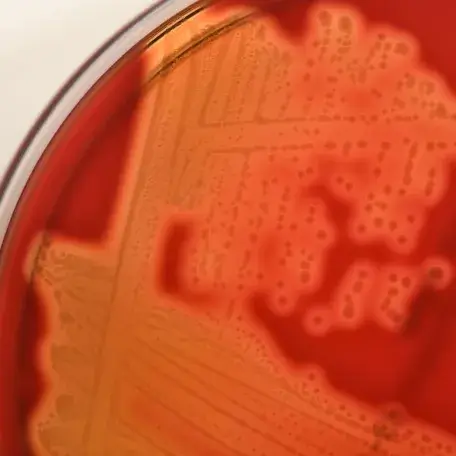

Our Hematology and Medical Oncology Division faculty are committed to the three pillars of state-of-the-art patient care: superior clinical care, research and an outstanding training environment. We treat patients with all cancer types, and those with benign hematological disorders.